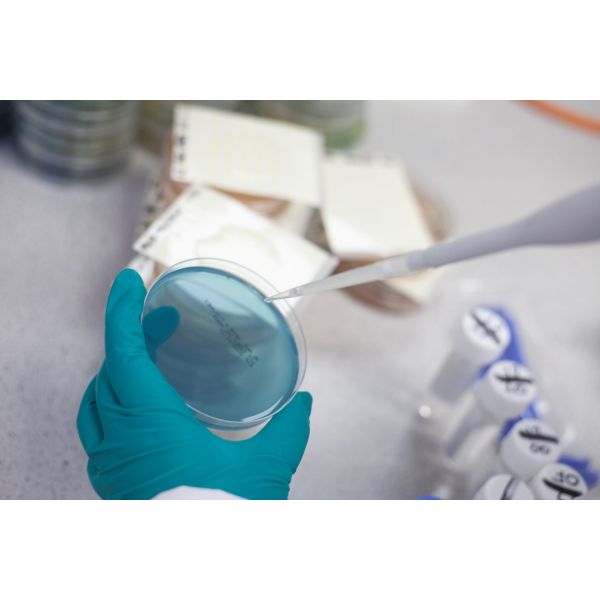
Potassium Sorbate Testing

Order before 2pm for UK next day shipping | US | EXPORT
Potassium Sorbate Testing
Analysis of potassium sorbate, which is used in beverages to inhibit yeast and mold growth, preventing refermentation in packaged products.
Availability:
Out of stock
SKU
LAB-POTSOR
The presence of Potassium Sorbate in beer and spirits must be monitored to comply with regulations and ensure product integrity.
Methods for Potassium Sorbate Testing:
High-Performance Liquid Chromatography (HPLC)
Most accurate method for detecting and quantifying potassium sorbate.
Separates and measures sorbate concentrations in complex beverages.
Spectrophotometric Analysis
Uses UV-Vis spectrophotometry to detect sorbate absorption.
A cost-effective but less precise alternative to HPLC.
Thin-Layer Chromatography (TLC)
A qualitative method for identifying potassium sorbate presence.
Enzymatic or colourimetric Assays
Rapid detection using specific reagents that react with sorbate.
Suitable for quick screening in breweries and distilleries.
Why Test for Potassium Sorbate?
Regulatory Compliance: Certain regions have limits on sorbate use in alcoholic beverages.
Fermentation Control: Prevents unwanted yeast activity in packaged products.
Quality Assurance: Ensures beer and spirits meet labelling claims and consumer expectations.
Testing potassium sorbate helps breweries and distilleries maintain product consistency, avoid off-flavours, and comply with safety standards.
| Vegan | No |
|---|
Need technical advice?
Find all the your TDS and SDS here.
Talk to the people in the know by calling one of our qualified brewers and winemakers on 0115 978 5494




Murphy & Son, Alpine Street, Old Basford, Nottingham, NG6 0HQ, United Kingdom.
Murphy & Son Ltd | 0115 978 5494 | Legal Pages